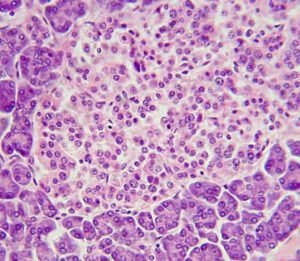

Nueva patente de Univalle representaría un gran avance para la cura de la diabetes
Correo electronico
info@orangecars.shop
Teléfono
Fijo: (602) 374 03 40
Horario de Atención
Lunes – Viernes: 08AM – 5:30PM
Sábados: 08AM -2:00PM
La Superintendencia de Industria y Comercio le otorgó a Univalle una nueva patente de invención en el área de la salud. Se trata de un método que, combinado con otros desarrollos en trasplantes adelantados por el Grupo de Investigación en Medicina Regenerativa, podría convertirse en una solución definitiva al problema de la diabetes.
La Superintendencia de Industria y Comercio le otorgó a Univalle una nueva patente de invención en el área de la salud. Se trata de un método que, combinado con otros desarrollos en trasplantes adelantados por el Grupo de Investigación en Medicina Regenerativa, podría convertirse en una solución definitiva al problema de la diabetes.
La patente, que fue concedida por 20 años mediante la resolución 844 de la Superintendencia, se denomina “Sistema y método de separación de corpúsculos inmersos, mediante inyección de fluido asistido con análisis computarizado de imágenes” y fue desarrollada por los profesores Rubén Jesús Camargo Amado de la Facultad de Ingeniería y José Óscar Gutiérrez Montes de la Facultad de Salud y la investigadora Carol Vanessa Díaz Vidal de la Escuela de Ingeniería Química.
Los islotes pancreáticos son agrupaciones de células que se encargan de la actividad endocrina. En ellos se acumulan varias hormonas producidas por el páncreas que son fundamentales para el funcionamiento del organismo como la insulina, facilitadora de la entrada de la glucosa a las células; el glucagón, una hormona de emergencia que se libera a la sangre para obtener una cantidad extra de azúcar cuando las reservas de insulina están muy bajas, y la somatostatina, que es fundamental para el crecimiento de los individuos y el funcionamiento y reemplazo celular.
En la diabetes tipo 1 hay una ausencia total de la producción de insulina por un daño en los islotes beta.
“Se logró determinar que la solución definitiva para la diabetes y sus complicaciones sería restaurar la función del islote. Para ello se han diseñado varias técnicas de obtención del islote sin necesidad de guardar o conservar el resto del páncreas.
Hasta ahora todos los esfuerzos por separar los islotes se han centrado en la separación químico-mecánica, es decir, a partir de un páncreas humano donado para trasplante, se separan hasta cierto punto las uniones de los islotes con el resto del páncreas por medio de enzimas y después se terminan de separar en forma mecánica por concusión con bolas de acero.
Dicho método tiene una efectividad regular pues la pérdida de islotes por trauma es muy grande: de un páncreas humano escasamente se obtiene una quinta o sexta parte del número original de islotes, por lo tanto, cualquier método que permita obtener los islotes sin dañarlos aumenta la cantidad disponible para el trasplante y disminuye el trauma que estas células pudieran tener en el curso de la separación. Entre estos métodos están las formas de separación electromagnéticas u ópticas, que garantizarían una mejor viabilidad y funcionalidad”, indica el profesor José Oscar Gutiérrez Montes, parte del equipo de investigación que acompañó al profesor de la Facultad de Ingeniería Rubén Camargo Amado en el desarrollo de esta invención.
La resolución de la patente señala que la Superintendencia consideró, entre otros aspectos, el efecto técnico del método patentado por los investigadores de Univalle: “consiste en que permite identificar y separar de forma eficiente islotes pancreáticos al interior de muestras microfluidas, estableciendo un tamaño específico de los islotes y mejorando el proceso de segmentación de los mismos”- y agrega que- “Sumado a lo anterior, la materia reivindicada, es susceptible de aplicación industrial”.
En el método tradicional de obtención de islotes para trasplante se toma el páncreas y se separan tejidos por acción de enzimas y después se lleva a cabo una separación mecánica. Los islotes son separados por diferencias de densidad, pues se supone que tienen una densidad diferente de las otras células que están en el páncreas.
“En el método desarrollado en esta patente decidimos no separarlos por densidad, teniendo en cuenta que las diferencias en este aspecto son relativamente cortas y al final se pierden muchos islotes por dicha razón, además de que ese proceso involucra un gran esfuerzo para separar y romper tejidos”, indica el profesor Rubén Camargo Amado, titular de la patente.
Los investigadores encontraron que los islotes se podían cambiar de color para diferenciarlos del resto de las células. Usaron un compuesto al que solo reaccionan los islotes y los tiñeron de rojo, mientras que el resto de las células permanecen traslúcidas. En esta invención usaron un sensor óptico, construyeron un micro canal y por él hicieron pasar todas las células. A medida que transitan frente al sensor óptico, este detecta los islotes por su coloración, facilitando la separación a través de un dispositivo que los empuja a otra cámara.
“Este sistema es extremadamente efectivo, pues separa todos los islotes que pasan por allí como si fuera una línea de producción de una planta de embotellamiento. Con esto esperamos que el porcentaje de separación aumente y podamos llegar a que un solo donante sea suficiente para una persona que va a recibir el implante de islotes, pues el porcentaje actual de obtención de islotes de un páncreas es muy pequeño, lo que en términos prácticos significa que una persona que está enferma y necesita el trasplante de islotes requiere de tres donantes que sean perfectamente compatibles con ella”, señala el profesor Camargo.
Para el profesor Oscar Gutiérrez, este método de aislamiento de islotes implementado en conjunto con los avances en trasplantes que lleva a cabo la Universidad, en los que no se requiere el uso de inmunosupresión, representaría una solución de salud pública costo efectiva, que abarcaría a un segmento mucho más grande de la población que el que actualmente se beneficia de estos tratamientos.
Según datos del Registro Mundial de Trasplantes, en el año 2019 se hicieron en todo el mundo alrededor de 150 mil trasplantes, mientras que en Colombia se realizaron apenas 600. “Para ponerlo en perspectiva, la relación del tipo de trasplante en el mundo podría ser esta: 100 mil trasplantes son de riñón, en pacientes con falla renal terminal, de los cuales un tercio sufren de diabetes. Alrededor de 38 mil son de hígado, 7 mil de corazón, 4 mil de pulmón y apenas unos 400 de páncreas completo y 200 de intestino. Lo anterior muestra como la diabetes, una de las enfermedades de mayor prevalencia, es de las que menos tiene trasplantes”.
Según la Organización Mundial de la Salud, aproximadamente 422 millones de personas en todo el mundo tienen diabetes. Cada año, 1.5 millones de muertes a nivel global se atribuyen a esta enfermedad. Tanto el número de casos como la prevalencia de diabetes aumentaron considerablemente en las últimas décadas.
Por: Yizeth Bonilla Vélez
"*" señala los campos obligatorios
Vocación de servicio al cuidado de tu salud
Correos electrónico
Información General
info@orangecars.shop
rehabilitarteencasa@gmail.com
Servicio al Cliente
servicioalcliente@orangecars.shop
Medicina Prepagada
aseguradospoliza@orangecars.shop
Radicación de Factura Electrónica
900459820@recepciondefacturas.co
Selección de Personal
coordinacion@orangecars.shop
Horario de Atención
Lunes – Viernes: 08AM – 5:30 PM
Sábados: 08AM -2:00PM
Dirección
Cra 46 # 9c – 85 Consultorio 603 Cali, Valle del Cauca
Solicitud de Citas
Fijos: (602) 374 03 40 – (602) 374 05 50
Móvil: 316 024 04 55 – 320 590 47 17
Enlaces de Interés
[popup_trigger id=”5064″ tag=”Historia Clínica ” do_default]Historia Clínica[/popup_trigger]
[popup_trigger id=”5731″ tag=”Registrarme”]Registrarme [/popup_trigger]
Políticas
[popup_trigger id=”6395″ tag=”Política de Calidad “]Política de Calidad [/popup_trigger]
[popup_trigger id=”6364″ tag=”Seguridad del Paciente”]Seguridad del Paciente [/popup_trigger]
[popup_trigger id=”11219″ tag=”Tratamiento de Datos”]Tratamiento de Datos [/popup_trigger]
